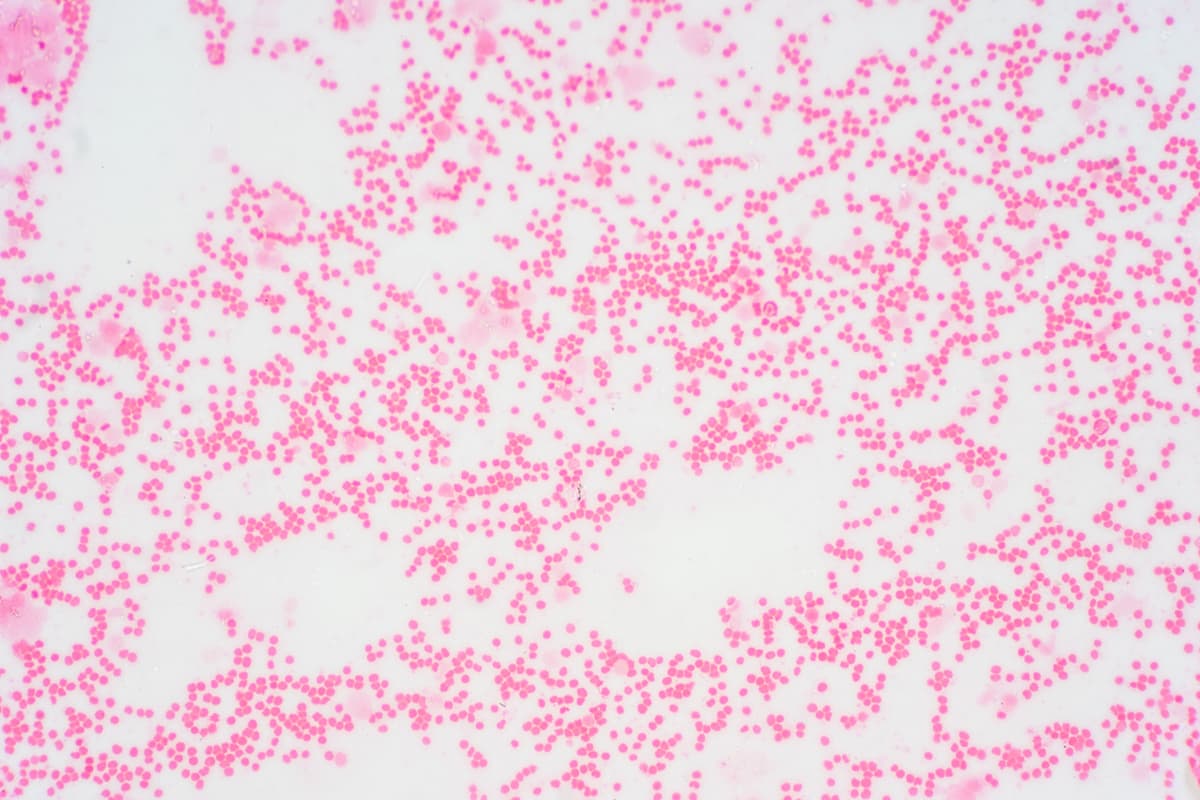

February 12, 2025
Author(s): Luke Halpern, Assistant Editor
Patients with primary myelofibrosis (PMF) harboring the cytopenic phenotype called cytopenic (CyP) PMF face greater unmet needs and worsened prognosis compared with other myeloproliferative neoplasms (MPNs), including polycythemia vera (PV) and essential thrombocytopenia (ET), according to an analysis of data from the European multicenter collaborative ERNEST registry.1
Myelofibrosis that advances to blast phase worsens outcomes for patients affected. | Image Credit: © tonaquatic – stock.adobe.com
Disease behavior of MF can vary widely based on clinical phenotype. Two distinct subgroups comprise MF: proliferative MF and cytopenic MF, which is also called myelodepletive MF. For patients with cytopenic MF, disease presentation can encompass lower blood counts—specifically thrombocytopenia and anemia—additional somatic mutations, and a worse prognosis compared with proliferative MF.2
Additionally, approved Janus kinase (JAK) inhibitors that can improve constitutional symptoms of MF carry risks of worsening anemia and thrombocytopenia in CyP MF, making treatment uniquely challenging for patients. Severe anemia is known to further worsen patient prognosis, and measures to relieve disease burden, such as transfusions, can lead to disease progression into blast phase (BP) MF. Given the poor outcomes MF patients with CyP face, describing the clinical characteristics and outcomes of this population is critical.1,3
The current investigators analyzed data gathered from the European multicenter collaborative ERNEST registry, with a focus on the clinical outcomes and characteristics of MF patients with CyP. In total, 559 patients comprised the study population; a CyP was defined by the presence of at least 1 cytopenia at diagnosis, including sex-adjusted anemia, thrombocytopenia, or leukopenia. Patients who showed none of these characteristics were considered MyP.1
Median follow-up was 5.4 years. A CyP was identified in 275 patients (49.2%); these patients were more likely to be older, less frequently JAK2V617F-mutated, and included in higher risk categories. In total, 392 patients (70.1%) died, including 59.9% of MyP patients and 80.7% of CyP patients, and the incidence rate of death among patients with both anemia and thrombocytopenia was the highest among the subgroups analyzed.1